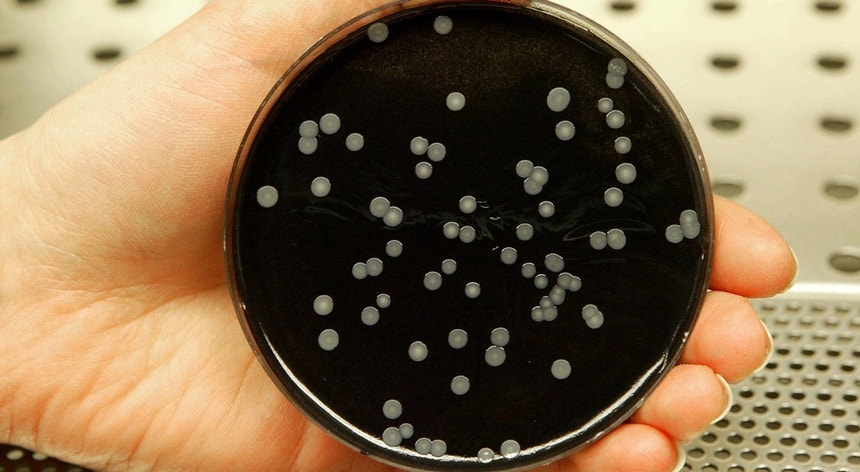

País
Saúde
Legionella, duas mortes em 30 casos diagnosticados
Um comunicado conjunto da Direção-Geral de Saúde e do Instituto Ricardo Jorge dá conta de 30 casos de Doença dos Legionários desde início de novembro com possível ligação epidemiológica ao Hospital de São Francisco Xavier. Destes casos registam-se duas vítimas mortais, ocorridas esta segunda-feira, naquele que é o mais grave surto de legionella desde 2014. O Ministério Público já está a investigar.
A Direção-Geral de Saúde (DGS) e o Instituto Ricardo Jorge (INSA) esclarecem em comunicado que foram registados, no total, 30 diagnósticos da Doença dos Legionários.
Dos 30 doentes, dois acabaram por morrer esta segunda-feira e um outro doente já teve alta. Os restantes encontram-se internados, tratando-se sobretudo de “idosos com fatores de risco associados”, nomeadamente doenças crónicas ou hábitos tabágicos.
O comunicado enviado esta segunda-feira às redações esclarece quais as primeiras medidas de controlo e precaução tomadas aquando da deteção dos três primeiros casos.
“Pelo princípio da precaução, foram tomadas as medidas adequadas para interromper a possível fonte de transmissão, designadamente choque térmico e químico no sistema de distribuição de água do Hospital e encerramento e tratamento das torres de refrigeração”, esclarece o documento.
As autoridades de saúde referem ainda que está em curso uma investigação epidemiológica nas vertentes da vigilância da saúde humana e ambiental, de forma a apurar as circunstâncias que deram origem ao surto, tendo para isso realizado vistorias a equipamentos e estruturas considerados potenciais fontes de transmissão.
Medidas de segurança "suficientes"
Por indicação do ministro da Saúde, as várias entidades estão ainda a elaborar um relatório conjunto “para esclarecimento da cadeia de acontecimentos que conduziram ao surto”, acrescentando que a avaliação e a concretização de todos os procedimentos necessários exigem, pelo menos, duas semanas.
As autoridades responsáveis referem que “as medidas de segurança adotadas prevêem-se suficientes para interrupção da transmissão e controlo do surto”, mas vão continuar a ser monitorizadas.
As administrações regionais de saúde do país vão ainda fazer uma "avaliação e gestão do risco" de todas as unidades de cuidados de saúde públicas, devido a este novo surto.
O comunicado conjunto surge poucas horas depois de o Ministério Público ter anunciado que vai “recolher elementos” sobre o surto de infeção com a bactéria legionella no hospital São Francisco Xavier.
Na segunda-feira, dois doentes morreram na sequência do surto de infeção, um homem de 77 anos e uma mulher de 70 anos.
Este é o segundo surto mais grave da Doença do Legionário nos últimos anos. Em 2014, 12 doentes acabaram por morrer e mais de 400 pessoas foram afetadas em Vila Franca de Xira.
Dos 30 doentes, dois acabaram por morrer esta segunda-feira e um outro doente já teve alta. Os restantes encontram-se internados, tratando-se sobretudo de “idosos com fatores de risco associados”, nomeadamente doenças crónicas ou hábitos tabágicos.
O comunicado enviado esta segunda-feira às redações esclarece quais as primeiras medidas de controlo e precaução tomadas aquando da deteção dos três primeiros casos.
“Pelo princípio da precaução, foram tomadas as medidas adequadas para interromper a possível fonte de transmissão, designadamente choque térmico e químico no sistema de distribuição de água do Hospital e encerramento e tratamento das torres de refrigeração”, esclarece o documento.
As autoridades de saúde referem ainda que está em curso uma investigação epidemiológica nas vertentes da vigilância da saúde humana e ambiental, de forma a apurar as circunstâncias que deram origem ao surto, tendo para isso realizado vistorias a equipamentos e estruturas considerados potenciais fontes de transmissão.
Medidas de segurança "suficientes"
Por indicação do ministro da Saúde, as várias entidades estão ainda a elaborar um relatório conjunto “para esclarecimento da cadeia de acontecimentos que conduziram ao surto”, acrescentando que a avaliação e a concretização de todos os procedimentos necessários exigem, pelo menos, duas semanas.
As autoridades responsáveis referem que “as medidas de segurança adotadas prevêem-se suficientes para interrupção da transmissão e controlo do surto”, mas vão continuar a ser monitorizadas.
As administrações regionais de saúde do país vão ainda fazer uma "avaliação e gestão do risco" de todas as unidades de cuidados de saúde públicas, devido a este novo surto.
O comunicado conjunto surge poucas horas depois de o Ministério Público ter anunciado que vai “recolher elementos” sobre o surto de infeção com a bactéria legionella no hospital São Francisco Xavier.
Na segunda-feira, dois doentes morreram na sequência do surto de infeção, um homem de 77 anos e uma mulher de 70 anos.
Este é o segundo surto mais grave da Doença do Legionário nos últimos anos. Em 2014, 12 doentes acabaram por morrer e mais de 400 pessoas foram afetadas em Vila Franca de Xira.




